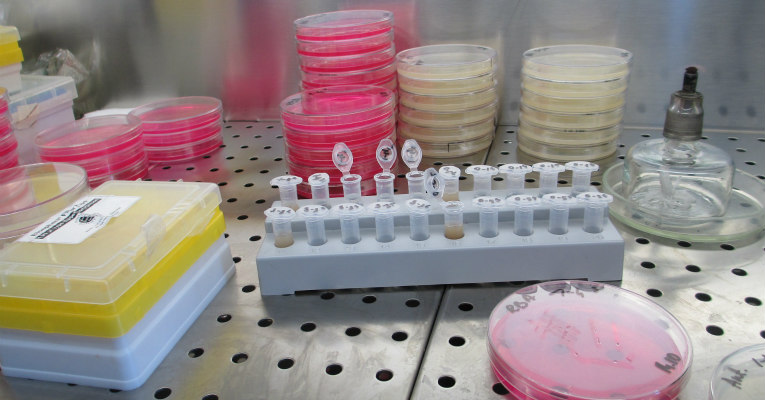

ONU premia cientista brasileira
Redação
[Via Correio do Estado]
Ela desenvolve uma pesquisa que busca desenvolver medicamentos para o tratamento do zika vírus e da doença de Chagas. Os estudos se debruçam sobre moléculas capazes de alterar o vírus e o protozoário que causam essas doenças, para inibi-los.
De acordo com a pesquisadora mineira, já foram analisadas mais de 400 mil moléculas em complexos programas computacionais e algumas delas foram identificadas como “promissoras”.